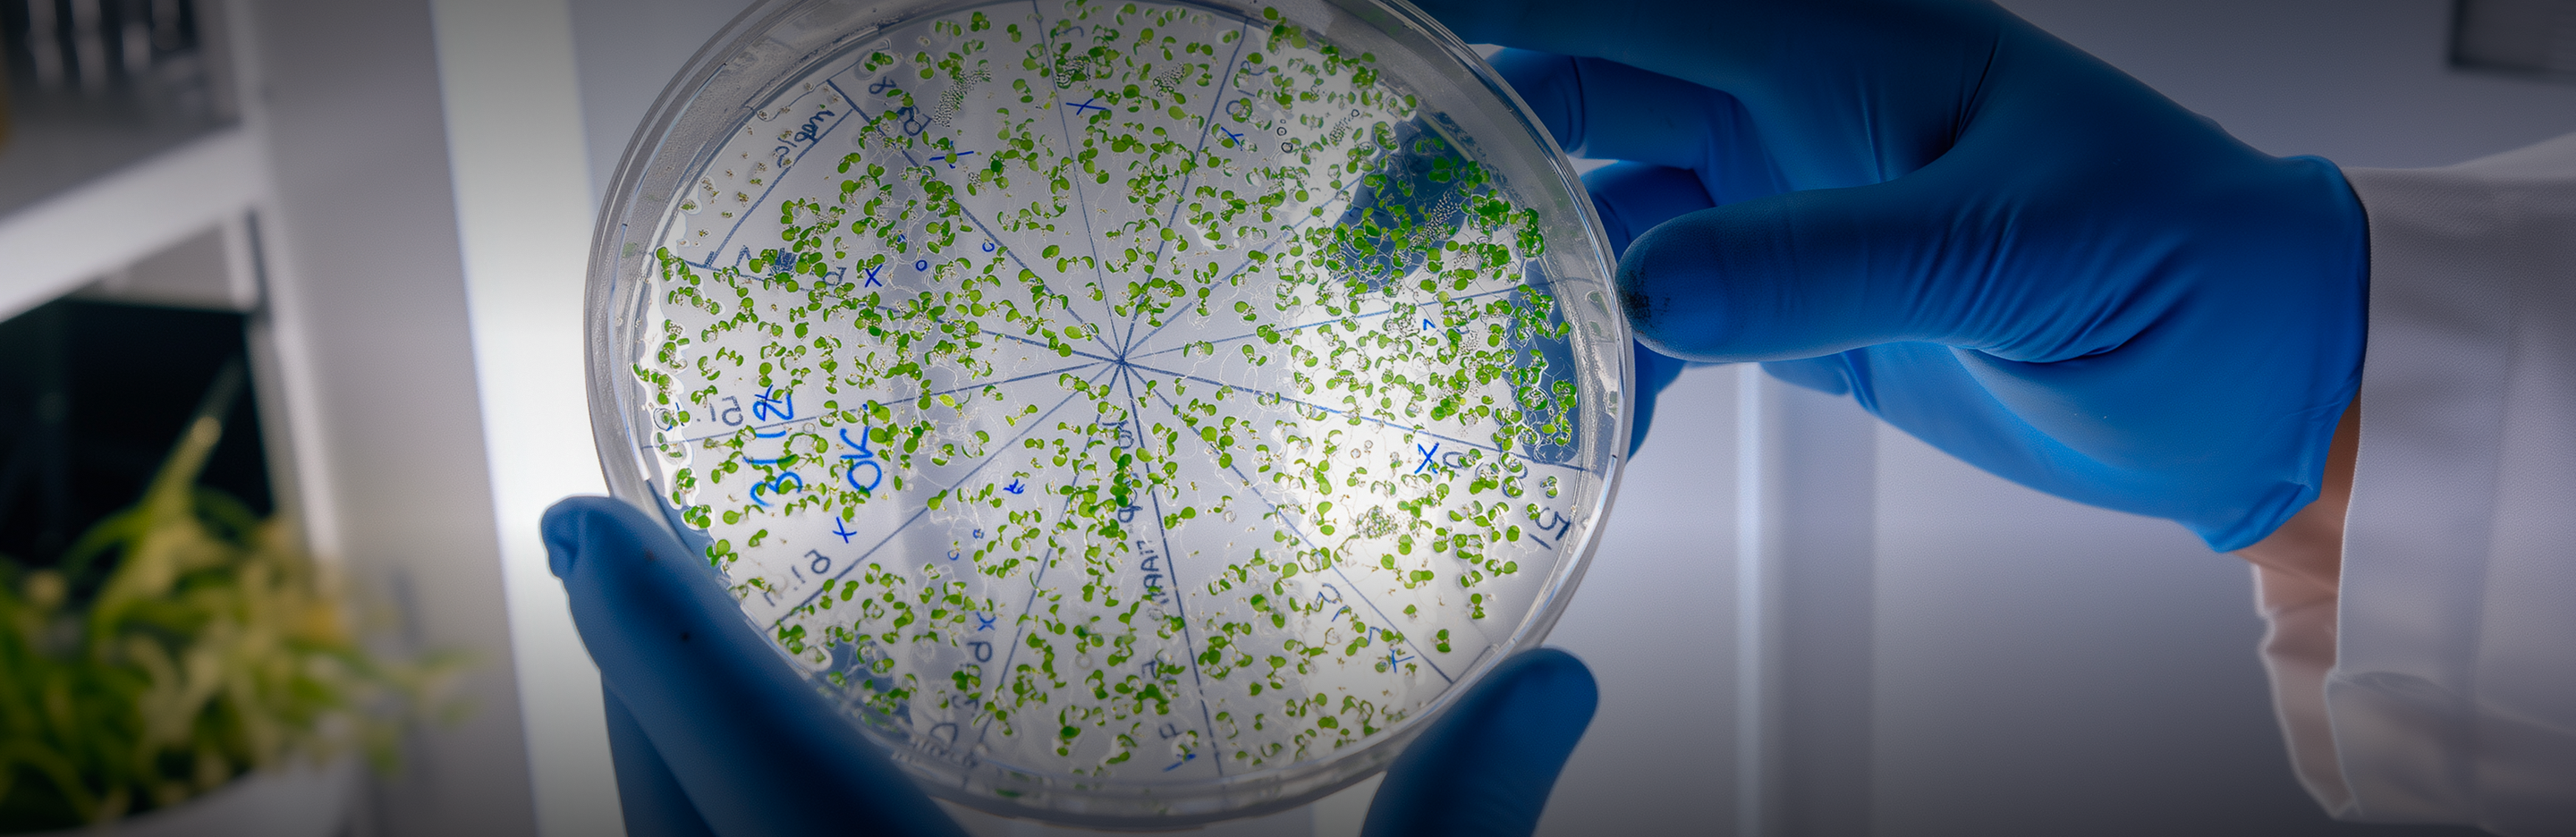
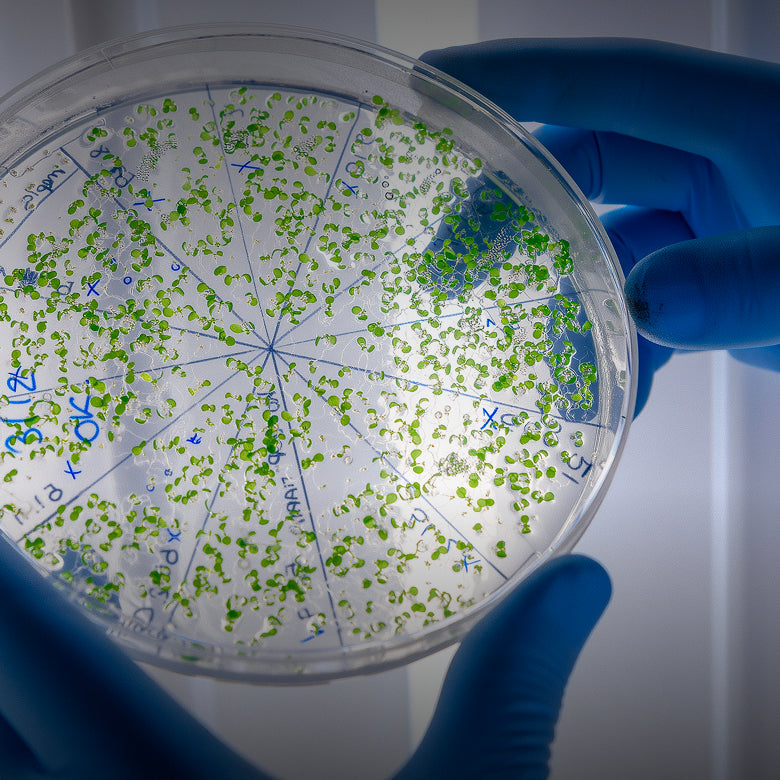

Advanced Materials
AI-powered material research and discovery
Additive manufacturing and material extrusion technologies
High performance membranes, composites, substrates and bio-engineered inputs
Advanced battery chemistries and new photovoltaic materials
Smart coatings and thermal super materials
Nanomaterials and nanoparticle formulations
AI-powered material research and discovery
Additive manufacturing and material extrusion technologies
High performance membranes, composites, substrates and bio-engineered inputs
Advanced battery chemistries and new photovoltaic materials
Smart coatings and thermal super materials
Nanomaterials and nanoparticle formulations